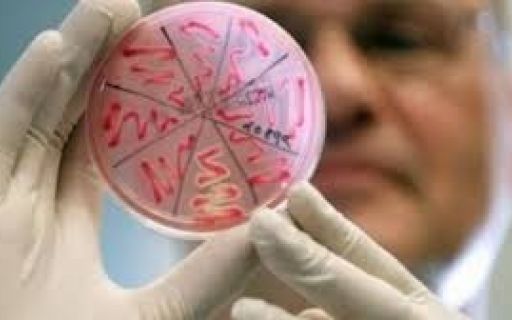

Свежие новости
Уполномоченный по правам человека Людмила Денисова в четверг, 9 августа, сообщила, что получила от российского омбудсмена Татьяны Москальковой новые фото украинского заключенного Олега Сенцова.
Бывшие бойцы спецроты милиции "Торнадо" забаррикадировались в камерах Лукьяновского следственного изолятора. Утром обвиняемых экс-бойцов роты "Торнадо" должны были этапировать, однако задержанные оказали сопротивление и забаррикадировались в камерах
Группе украинских ученых удалось обнаружить самый древний колодец на территории нашей страны - уникальная памятка истории расположилась на Бабиной горе в Олевске, что в Житомирской области
В 2018 году в Украине зафиксирован нерадостный рекорд — минимальное количество выпускников школ в истории страны. На это повлияла сложная демографическая ситуация, которая отразилась и на украинских университетах
Первый заместитель главы Национальной полиции Украины отчитался о ходе расследования убийства ветерана АТО Виталия Олешко, известного под позывным "Сармат" - рассматриваются три версии преступления
Уникальную находку удалось обнаружить группе археологов из университета Сапиенца в Риме - ученые откопали останки человека, у которого вместо руки было огромное лезвие - в сети его уже прозвали первым в мире "киборгом"
Зафиксирован первый случай листериоза − заражения бактерией, которая у человека вызывает множество серьезных заболеваний. В Украину она могла попасть из Европы, где стала причиной смерти десяти человек
Вчера, 8 августа, в Одессе должна была состояться встреча с нобелевским лауреатом, белорусской писательницей Светланой Алексиевич. Увы, мероприятие пришлось отменить, из-за угроз, которые поступили в адрес гостьи и организаторов
В Днепре несовершеннолетняя девушка родила тройню. Двоих из деток пытаются спасти в реанимационном отделении. Все трое деток – девочки. Вес одной из них составляет чуть более 800 грамм
Родные и друзья манекенщика Рика Дженеста, который на прошлой неделе якобы выбросился из балкона, не считают смерть Zombie Boy суицидом. Родственники погибшего озвучили свою версию произошедшего
В Виннице до конца 2019 года планируется построить завод по производству солнечных панелей. Отмечается, что новое предприятие будут строить в две очереди по 200 МегаВатт каждую.
Как уведомляет пресс-служба Национального агентства по предотвращению коррупции, МВД ответственные высокопоставленные чиновники не уведомили Нацагентство о 30 инцидентах, когда подчиненные не вовремя или вовсе не представили свои декларации.
Печерский районный суд Киева дал разрешение на задержание бывшего президента Украины Виктора Януковича, экс-министра внутренних дел Украины Виталия Захарченко бывшего начальника ГУ МВД Украины в Киеве Валерия Коряка.
Глава МОН Лилия Гриневич рассказала о 10 заведениях высшего образования, где объем госзаказа был расширен в сравнении с 2017 годом. По словам министра, за всю историю независимости Украины именно сейчас меньше всего выпускников школ.
Ученые из обсерватории массачусетского технологического университета обнаружили огромную дыру в ионосфере земли. Ученые опасаются, что новообразование может спровоцировать сбои во многих земных системах, в том числе GPS.
В США группа сенаторов предложила отключить РФ от мировой долларовой системы. Проектом предлагается объявить Россию страной-спонсором терроризма и заблокировать долларовые расчеты для ключевых участников банковской системы государства.
В Англии в графстве Дербишир во время пожара на фабрике пластиковых изделий Ravensbourn Plastics Ltd. поднялся огненный торнадо высотой не менее 15 метров.
Спустя всего три дня, после землетрясения в Индонезии на острове Ломбок, снова зафиксированы подземные толчки, магнитуда которых достигала 6,2 баллов по шкале Рихтера. Люди в панике покидают дома.
В интернете появился новый трейлер киноленты "Щелкунчик и четыре королевства", история которого слегка изменит классический сюжет сказки Гофмана и балета Чайковского. Но в центре неизменно предстанет девушка Клара.
Американская киноакадемия приняла решение учредить новую номинацию премии "Оскар" - "Лучшее популярное кино", а также сократить телеверсию церемонии вручения до трех часов.

Продовжуючи перегляд сайту inform-ua.info, ви підтверджуєте, що ознайомилися з
Продовжуючи перегляд сайту inform-ua.info, ви підтверджуєте, що ознайомилися з